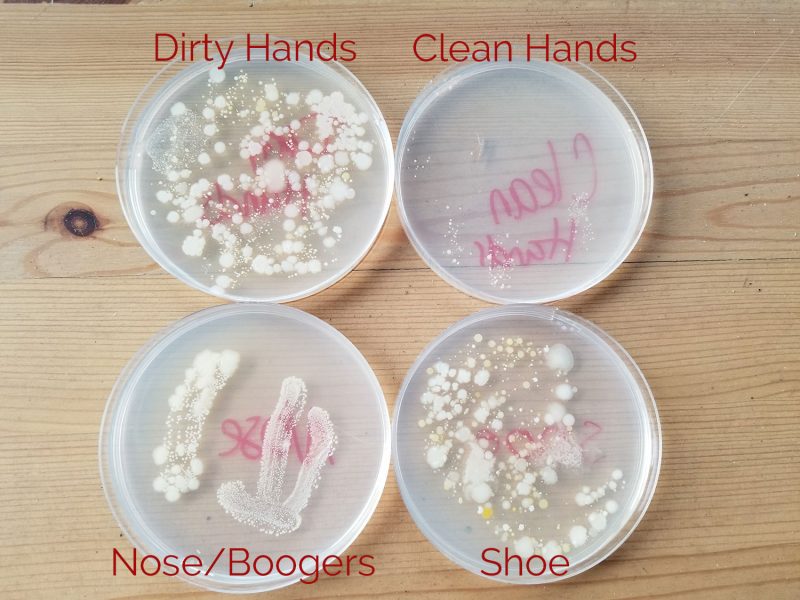

Let’s Talk About Germs

The idea of germs is a bit abstract, especially to a kid. We’ve read about germs and watched Curious George deal with Toots the germ. He grasps the concept but, to help give a visual and make the concept more real, I decided we’d do a little experiment at home.
I shopped around and ended up ordering a few petri dishes with agar from Amazon. I found a few recipes for making your own agar, but read reviews with mixed results. And pre-made petri dishes just seemed like the easier option.
The package came with 10 petri dishes. For this round, we only used 4 dishes. First, dirty hands from just playing around the house. Second, freshly washed hands using soap (not antibacterial, just regular soap). Third, I told him to pick his nose and wipe it on the dish. This got some funny looks since I’m usually saying things like “OMG! Stop picking your nose! That’s gross!” Lastly, we took his flip flops and pressed the bottom of the shoe into the agar.
We keep it nice and cool inside the house so I placed the covered petri dishes in a clear plastic bin and put the bin on the back patio where they would be in the shade. Can’t have any sunlight killing of our germs! We checked on them the next morning and again in the afternoon. There was clear growth pretty early on, but I let them continue to sit outside just to see how nasty they would get.
48 Hours Later
I think the results speak for themselves. He is thoroughly grossed out. And I haven’t had to remind him to use hand soap since we did this experiment on Friday.
- Dirty Hands – 48 hour germ growth
- Clean Hands – 48 hour germ growth
- Nose/Boogers – 48 hour germ growth
- Shoe Bottom – 48 hour germ growth
Why Germs?
This may not be the most exciting activity for kids, but in the midst of a global pandemic, it’s not a bad idea to have the conversation. Talking about germs in general felt like a less-scary way to emphasize the importance of hand-washing. Doing this little experiment gave that conversation a visual aid that makes it more real.
If you decide to do your own germ growth experiment, you can also personalize it. Think of all the gross things your kids do and touch. I know I plan to do a second round. This time I will swab the hamsters feet to hopefully show why we always wash our hands after holding him. We’ll also test a door knob and maybe the toilet flusher to show how germs can live on objects around the house. Though, I’m not entirely sure I want to know…